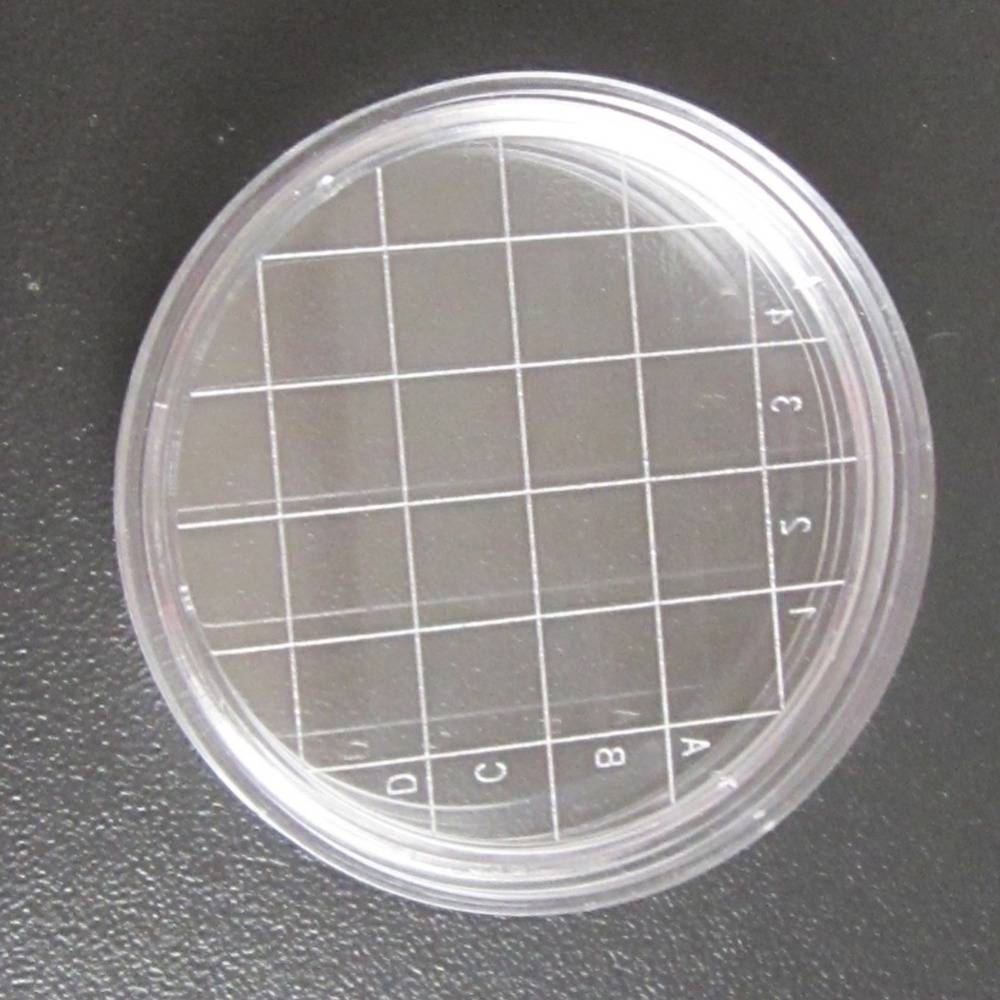

Блюдо для бактериальной культуры













6,5 см (сетка)

Блюдо для клеточной культуры








Отзывы о других товарах
[2019-12-12 21:31:33]Алексей: Аппарат просто пушка-бомба! Это хит года определённо. Всё сделано просто на 5+ и тактильно и визуально он смотрится достаточно дорого. Снимает шикарно на основную. Может быть чуть шумноват в сумерках, но зато детализация за счет 64 мп на высоком уровне. Я ...Читать полностью...
[2019-12-12 22:36:55]Александр: Заказали с женой данный девайс в подарок ее отцу, так как он в последнее время стал очень плохо слышать и врачи прописали слуховой аппарат. Дождались доставку ,спасибо этому сайту, отличный русскоязычный аналог AliExpress без этих кривых описаний и прочего. Аппарат оказался ...Читать полностью...
[2019-12-13 19:36:39]Оксана : Отличные брюки за такую цену, я даже не ожидала думалала по качеству будет хуже, а нет. Заказала брюки мужу на Aliexpress, приятная, довольно таки не тонкая ткань, на весну и лето самое то. Прадовец общительный всегда отвечал на вопросы быстро, он ...Читать полностью...
[2019-12-12 22:51:26]Мила: Наверное, наиболее любимые мои аксессуары это те, которые я выбираю для своего телефона. И чаще всего я ищу их на aliexpress.В этот раз мой выбор на чехлы. В преддверии новогодних праздников хотелось чего-то более яркого и весёлого. И ярко-блестящие чехлы оказались ...Читать полностью...
[2019-12-12 23:53:36]Ольга: Слышала много положительных отзывов об интернет-магазине Aliexpress, но никак не решалась сделать заказ. Однако с рождением ребенка мое мнение поменялось, так как цены на одежду на Aliexpress значительно отличаются от магазинных. Я заказала комплект для малыша. Очень понравилось, что туда входит ...Читать полностью...